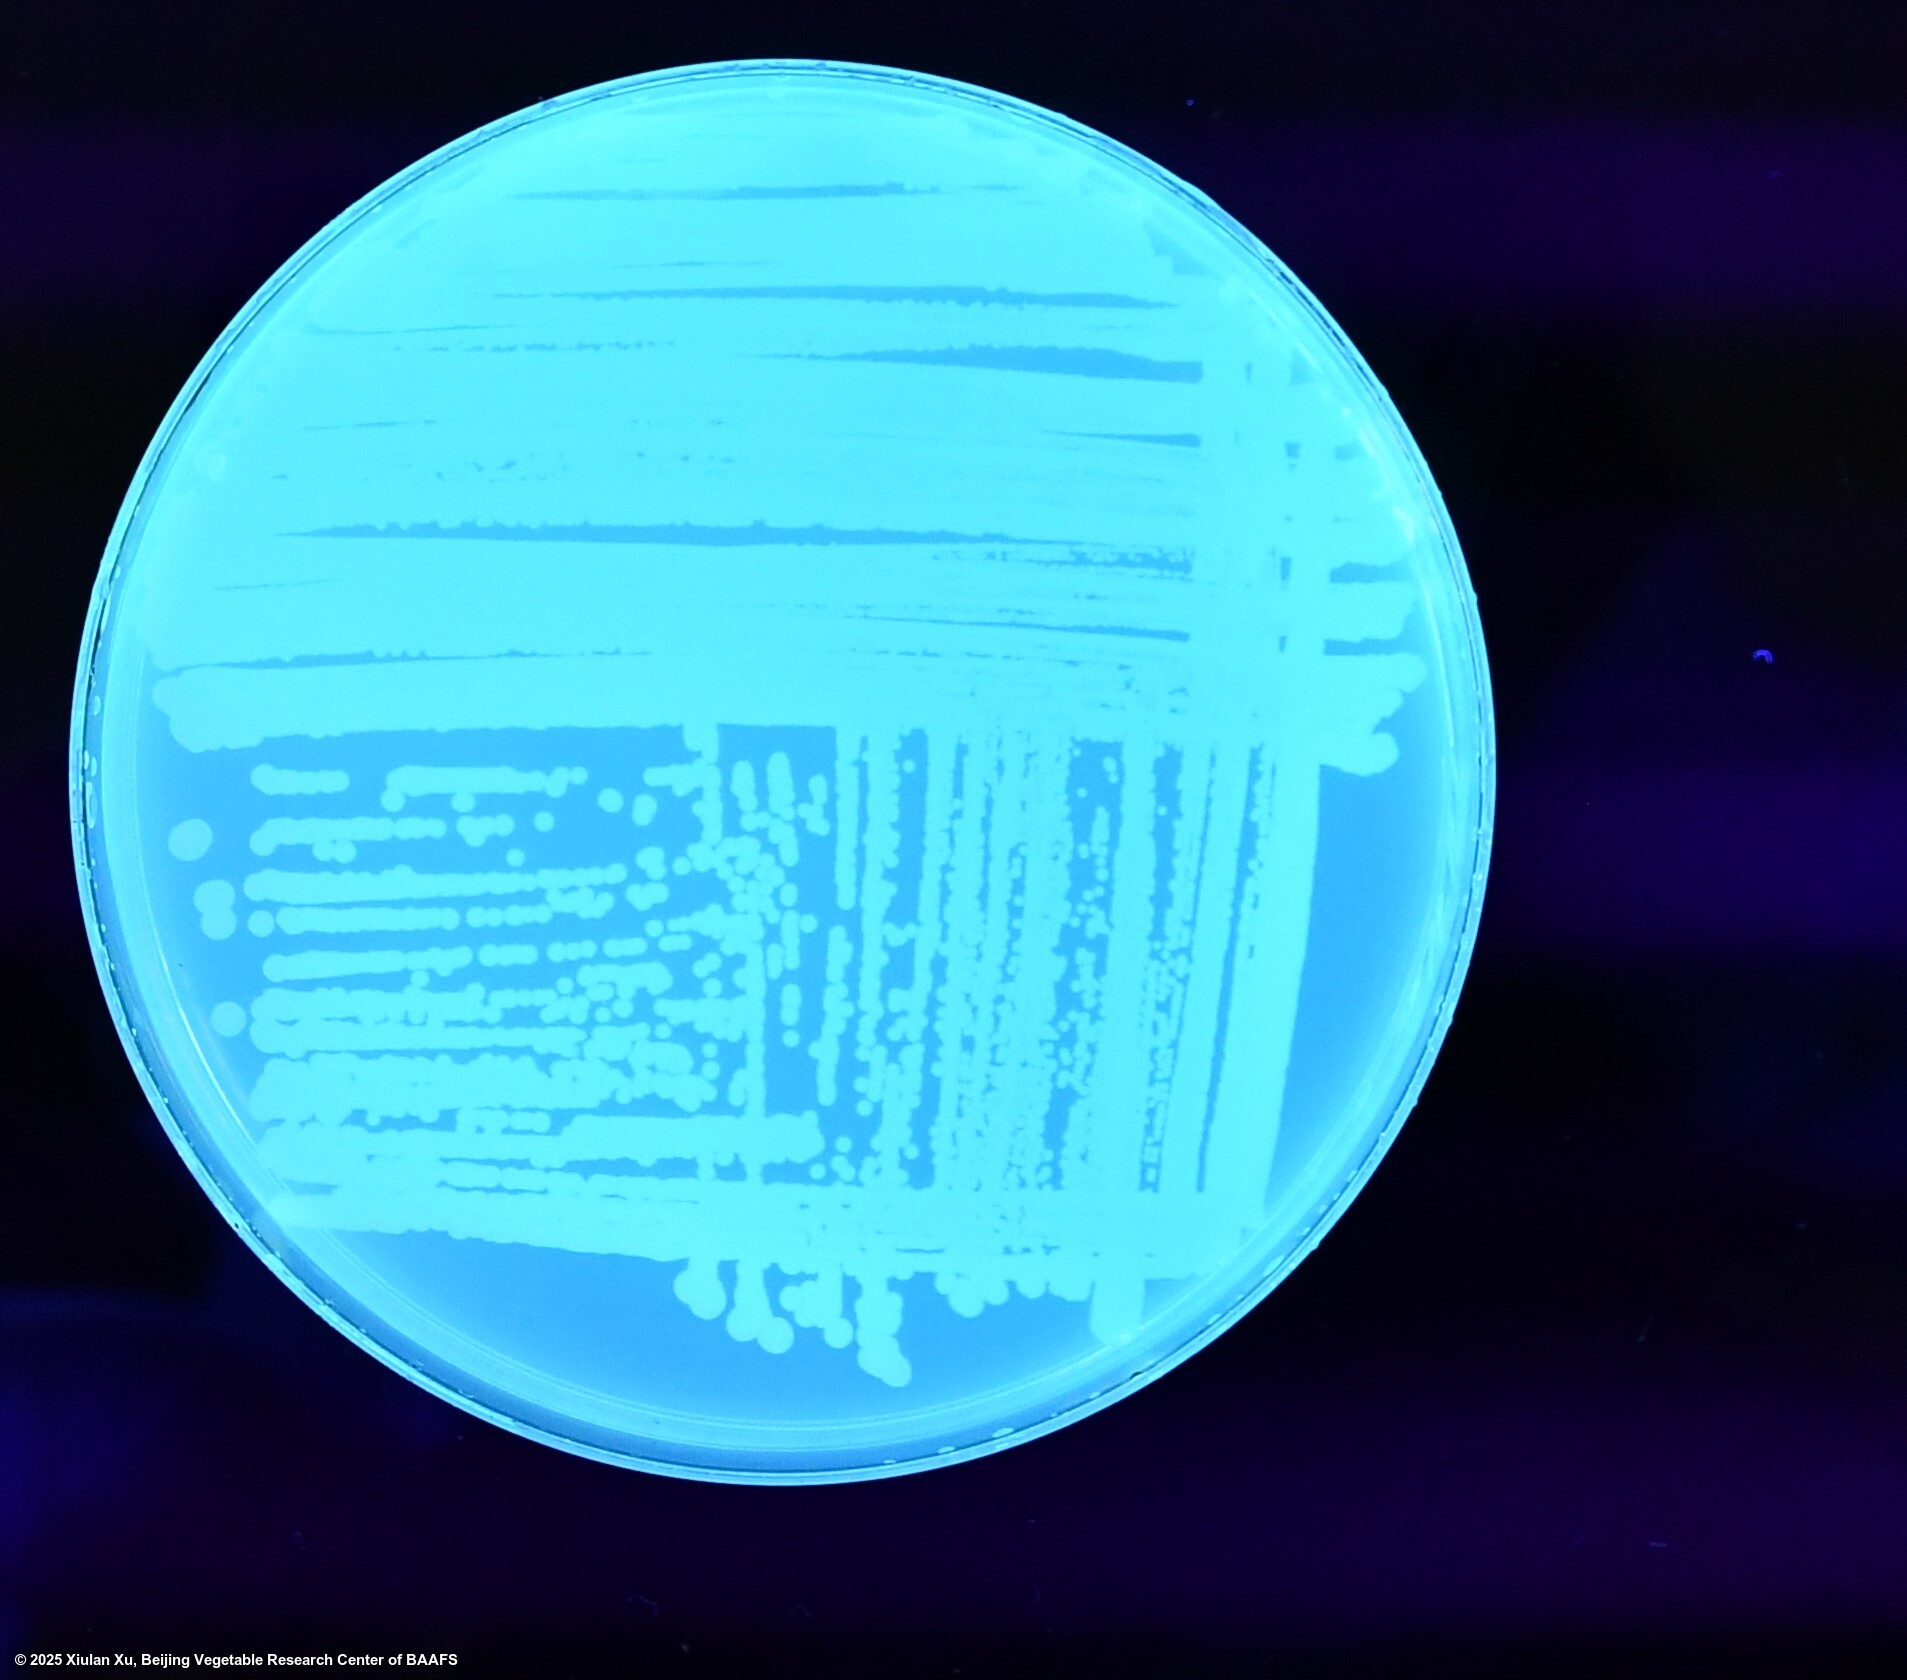

Pathogen
Pseudomonas syringae pv. lachrymans
Overview
|
Scientific name
|
Pseudomonas syringae pv. lachrymans |
|
Genus
|
Pseudomonas |
|
EPPO code
|
PSDMLA |
|
Common name
|
Bacterial spot of cucurbits |
|
Synonyms
|
Pseudomonas lachrymans |
Description
Pseudomonas syringae pv. lachrymans is the pathogen causing Angular leaf spot. It is most severe on cucumber, zucchini squash, and honeydew melon but also can infect muskmelon, cantaloupe, watermelon, other squashes, pumpkin, and various gourds.